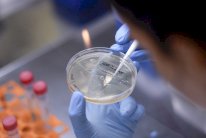
كورونا فيروس عادل... فهل يكون اللقاح ضده عادلًا أيضًا؟

نصر المجالي: رغم إعلانها عن تشكيل فريق عمل لدعم العلماء في محاولاتهم تحقيق ضربة منقذة للحياة في اطار الحرب مع فيروس كورونا، حذرت الحكومة البريطانية من أن إنجاز اللقاح سيستغرق "عدة أشهر" مع التأكد من ضمانات فعاليته.
وجاء التحذير على لسان وزير الأعمال ألوك شارما خلال المؤتمر الصحفي اليومي المعتاد الذي يعقد في داونينغ ستريت حول الاستجابة الحكومية لفيروس كورونا.
كما أصر كبير المستشارين العلميين في داونينغ ستريت السير باتريك فالانس على أن اللقاح لم يكن قاب قوسين أو أدنى وأن ضربة نهائية للقضاء عليه كانت "بعيدة بعض الشيء".
وتم تعزيز البحث عن لقاح فيروس كورونا من خلال إطلاق فريق عمل حكومي كبير المستوى من العلماء والباحثين والخبراء والاقتصاديين بقيادة كبير المستشارين العلميين السير باتريك فالانس ونائب كبير الأطباء البروفيسور جوناثان فان تام ، وذلك لدعم الجهود المبذولة لتطوير لقاح بسرعة في أقرب وقت ممكن.
وستكون من مهام الفريق بالإضافة إلى تزويد المؤسسات الصناعية والبحثية بالموارد والدعم، مراجعة اللوائح للسماح بإجراء تجارب لقاحات سريعة وآمنة.
كما أنه سيدفع باتجاه زياد التصنيع، بحيث عندما يتوفر اللقاح الذي ييمكن إنتاجه بسرعة وبكميات كبيرة.
مرحلة التحدي
وصعد الحديث عن انجاز لقاح ضد كورونا، حيث بلغت الازمة مرحلة التحدي، وقال باحثون بارزون إن المتطوعين البريطانيين يمكن إعطاؤهم الجرعة الأولى من اللقاح المحتمل لفيروس كورون خلال الأسبوع المقبل.
ويقوم علماء جامعة أكسفورد بالفعل بتصنيع مليون جرعة لتكون متاحة بحلول سبتمبر، مؤكدين أنهم واثقون من أنها ستثبت نجاحها، وبالمقابل يسعى الخبراء البارزون في جميع أنحاء العالم للعثور على لقاح، وسط مخاوف من عودة العدوى في موجات.
وقالت سارة جيلبرت، أستاذة علم اللقاحات في جامعة أكسفورد، التي تقود الفريق إن اللقاح يمكن أن يكون متاحًا للاستخدام من قبل عامة الناس بحلول الخريف.
واستدركت: ومع ذلك ، قالت إنه يوجد دائمًا مجهول ولا يمكن للعلماء التأكد من أن اللقاحات ستعمل. وأوضحت البروفيسورة جيلبرت بأنها واثقة بنسبة 80 في المائة من نجاح اللقاح. والقالت: أنا شخصياً لديّ درجة عالية من الثقة.
وأضافت: "هذه وجهة نظري، لأنني عملت مع هذه التقنية كثيرًا، وعملت في تجارب لقاح Mers، وقد رأيت ما يمكن القيام به. وأعتقد أن لديها فرصة قوية للعمل".
ولدى سؤاله عن موعد تسليم الجرعة الأولى من اللقاح لمتطوع تجريبي، قال البروفيسور أندرو بولارد ، رئيس الباحثين في الدراسة لتي تنفذها جامعة أكسفورد إن ذلك يعتمد على موعد اختتام الجزء الأخير من الاختبار من التصنيع، لكنه أضاف: "لكن يجب أن يكون ذلك خلال الأسبوع القادم أو نحو ذلك ، لكننا سنؤكد ذلك في أقرب وقت ممكن".
الاف المتطوعين
يذكر أن أكثر من 5000 مريض بالفيروس التاجي في المملكة المتحدة تطوعوا للمشاركة في تجربة دوائية تديرها جامعة أكسفورد لإيجاد علاج لـ COVID-19.
ويُطلق على البرنامج تجربة RECOVERY التجريبية (التقييم العشوائي للعلاج COV-id19) وهو أكبر تجربة فردية في العالم لعلاج فيروسات التاجية.
وحصلت الجامعة على دعم كبير الأطباء الحكوميين البروفيسور كريس ويتتي ووجهت نداء إلى الأطباء في جميع أنحاء البلاد لتسجيل المرضى في التجربة الطوعية.

5 آلاف متطوع سيخضعون للتجربة
وقد انضم المتطوعون منذ ذلك الحين إلى المحاكمة من أكثر من 160 صندوقًا من NHS في جميع أنحاء البلاد ويأمل العلماء في استمرار المزيد من الأشخاص في التسجيل.
ولم يضع الأطباء عددًا على عدد الأشخاص الذين تحتاجهم التجربة من أجل تحقيق النجاح ، لكنهم قالوا إنه كلما زاد عدد المشاركين في التجربة ، زاد احتمال أن يجد الفريق إجابات.
الادوية
وسيتلقى المشاركون أحد الأدوية الأربعة الموجودة حاليًا في السوق - بما في ذلك عقار مكافحة الملاريا الذي يروج له دونالد ترمب، المعروف باسم هيدروكسي كلوروكوين.
وتشمل الأدوية الأخرى التي يتم النظر إليها كعلاج لـ COVID-19 مزيجًا من Lopinavir و Ritonavir (المعروف باسم العلامة التجارية Kaletra) ، والذي يستخدم لعلاج فيروس نقص المناعة البشرية ؛ جرعة منخفضة من ديكساميثازون، الستيرويد المستخدم لتقليل الالتهاب ؛ والأزيثروميسين ، مضاد حيوي شائع الاستخدام.
سباق شديد
يشار إلى أن هناك ثلاثة مرشحين رئيسيين للقاحات، واحد من الصين واثنان من شركات في الولايات المتحدة، تم الكشف عنه في وقت سابق من هذا الأسبوع.
وكان علماء طوروا 67 لقاحًا آخر في جميع أنحاء العالم بما في ذلك فرق من المملكة المتحدة، يعملون أيضًا على إجراء تجارب على البشر.
وتظهر قائمة الأبحاث أن معهد بكين للتكنولوجيا الحيوية ، الذي يعمل مع CanSino Bio في هونغ كونغ ، يقود عملية اللقاح التي يطلق عليها Ad5-nCoV.
وفي لوحة بورصة هونغ كونغ، قالت CanSino Bio إنها تخطط للانتقال إلى المرحلة الثانية من التجارب مع مرشح اللقاح في الصين "قريبًا".
ومن بين شركات الأدوية التي تتخذ من الولايات المتحدة مقراً لها، حصلت Moderna ومقرها ماساتشوستس على الموافقة التنظيمية للانتقال إلى التجارب البشرية في الشهر الماضي.
كما تلقى خمسة وأربعون مشاركًا في سياتل الخزعة التجريبية - التي تم تطويرها مع المعاهد الوطنية للصحة (NIH) - في مارس لاختبار سلامتها. وقالت مصادر علمية إنه ليس هناك فرصة لإصابة المشاركين من الخزعات، لأنها لا تحتوي على الفيروس نفسه.
وكانت شركة Moderna اتخذت طريقًا مختلفًا لتقنيات اللقاحات التقليدية. وعادة يتم زرع حشرة ضعيفة في الجسم - مثل لقاح الحصبة والنكاف والحصبة الألمانية، لكن الشركة ترى أن الحمض النووي الريبي المرسال يحفز الجهاز المناعي على إنتاج بروتينات مشابهة للفيروس القاتل، الذي يمكنه بعد ذلك مكافحته.
ومن جهتها، بدأت Inovio Pharmaceuticals ومقرها بنسلفانيا تجاربها البشرية الأسبوع الماضي على 40 متطوعًا صحيًا في فيلادلفيا وميسوري.
يذكر أن نهج Inovio هو ما يسمى لقاح الحمض النووي، المصنوع باستخدام جزء من الشفرة الجينية للفيروس المعبأة داخل قطعة من الحمض النووي الاصطناعي.

التعليقات